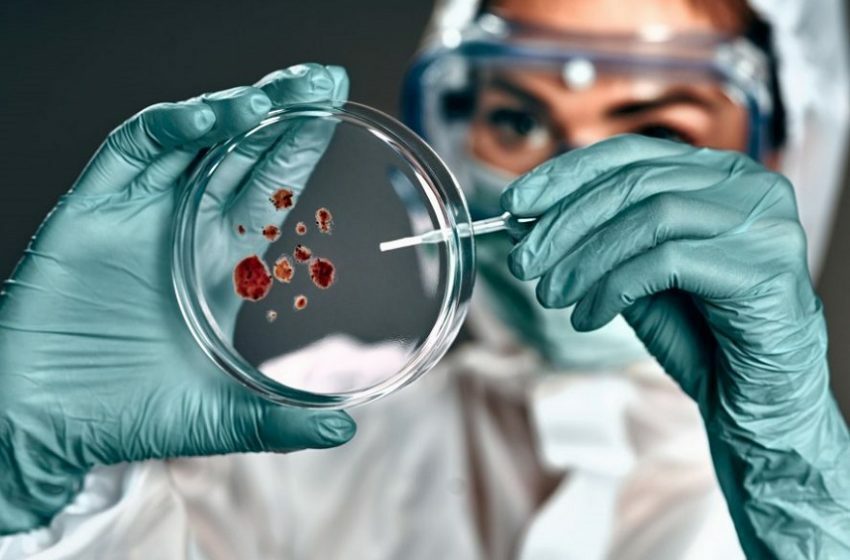

A ATBeHELP é uma plataforma interoperável sustentada em algoritmos de decisão que permitem a interpretação, análise e integração com os sistemas de informação laboratoriais e clínicos.
Integramos em algoritmos os dados microbiológicos e informações sobre a prescrição de antibióticos, facilitando a escolha do tratamento mais adequado para cada caso clínico e permitindo que cada Unidade Local do Programa de Prevenção e Controlo das Infeções e Resistência aos Antimicrobianos e os serviços farmacêuticos determinem a dose diária definida recomendada por doente.
Toda esta informação será sustentada nas guidelines mais atualizadas da prescrição antibiótica.
Missão:
Capacitar os profissionais de saúde com uma plataforma inteligente e acessível, que otimiza a prescrição do antibiótico, promove o seu uso responsável e contribui para a redução da resistência antimicrobiana, melhorando os resultados clínicos e a saúde da população.
Visão:
Ser um instrumento de referência em soluções de apoio à decisão clínica na área da antibioterapia, transformando a prática médica, através da inovação tecnológica e da gestão eficaz da informação, para um futuro com antibióticos eficazes, resultando em cuidados de saúde de excelência.
Valores:
Excelência: Atingir a mais alta qualidade em todas as soluções e serviços, com rigor científico e inovação contínua.
Foco no Paciente: Colocar o bem-estar do paciente no centro de todas as decisões, promovendo cuidados seguros, eficazes e personalizados.
Colaboração: Trabalhar em parceria com profissionais de saúde, instituições e outras partes interessadas, fomentando a comunicação e o trabalho em equipa.
Responsabilidade: Promover o uso consciente e responsável dos antibióticos, contribuindo para a sustentabilidade dos sistemas de saúde e para a saúde pública.
Inovação: Procurar, constantemente,
novas soluções e tecnologias para melhorar a prática clínica e enfrentar os desafios da resistência antimicrobiana.
Ética: Agir com integridade, transparência e respeito, garantindo a privacidade e a segurança dos dados dos pacientes.
Sustentabilidade: Promover práticas que garantam a viabilidade a longo prazo dos sistemas de saúde, o uso eficiente dos recursos e a minimização do impacto ambiental.
Fundação Gulbenkian selecionou 12 unidades portuguesas para o projeto. Pneumonias, infeções associadas a cateteres e a algumas suturas são os principais alvos do programa.

Testes à resistência a antibióticos serão os "primeiros desenvolvidos em Portugal" para tornar mais eficiente a resposta a "um dos maiores problemas de saúde pública".

SEGUNDA-FEIRA
9:00 am - 6:30 pm
TERÇA-FEIRA
9:00 am - 6:30 pm
QUARTA-FEIRA
9:00 am - 6:30 pm
QUINTA-FEIRA
9:00 am - 6:30 pm
SEXTA-FEIRA
9:00 am - 6:30 pm